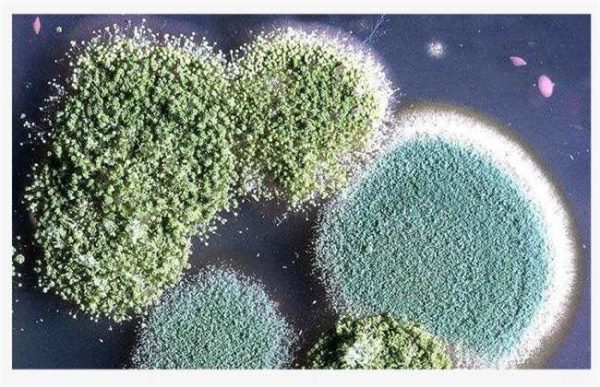
虾用什么菌好

虾是近几年市场上非常热销的一种水产养殖,但是养虾也是存在一定的技术难度的。近期有很多的朋友就在咨询,养虾要用哪种菌比较好?有哪些适合用于养虾的菌类?用什么菌核养殖什么品种的虾有没有什么关系?等等诸如此类的问题。其实在这一块如果要深入了解的话,还需要自己去研究和学习,不过今天小编在这里给大家推荐几种目前来说对养虾还不错的菌类,大家可以参考一下。

1、EM菌
EM菌是近几年养虾中最常用的一种菌类。它可以最大限度的提高饲料的利用率,同时还能提高虾的免疫力,起到抗病虫害的作用,从而提高虾的产量和品质。其次就是EM菌还能起到净化水质的作用,这样就可以减少换水的次数。但是要注意的就是,在使用的时候,不要和其他的药剂一同使用,否则不仅不能达到想要的效果,还会造成水污染,引发虾群发病甚至死亡。

2、芽孢杆菌
芽孢杆菌中其实以枯草芽孢杆菌的效果最佳,其主要的作用就是用于净化水质,控制水体重微生物的生长;同时还能促进藻类的光合作用,增强水体溶解氧;还有就是能够维持水体清澈度。从它的所有作用来说,最强的就是净化水体的作用,但在使用的时候最好是在晴天的上午使用,同时要选择优质的枯草芽孢杆菌,否则也会污染养殖水体。

3、乳酸菌
乳酸菌它主要是用于抑制细菌的生长和杀菌灭菌;其次就是它还能起到促进消化,提高食欲的作用,从而缩短养殖周期;同时还能进行排毒解毒,增强虾群的排毒功能,提高虾群的质量;最后就是还具有分解的作用,可以改善养殖的水体质量。在使用乳酸菌的时候我们要注意的就是它的用量,在不同的时间段投放的话,那么它所需的量也是不同的,需要按照说明书的要求来进行。
4、酵母菌
说道酵母菌其实大多数的人都对它比较了解,那么为什么说养虾的时候用酵母菌的效果也很好呢?那是因为酵母菌它具有很好诱食性,并且还能给虾群提供大量的但蛋白质菌体,从而加快虾群生长的速度。其次就是酵母菌还能起到调节水体中微生物的作用,提高饲料的利用西欧阿绿。不过在使用酵母菌养殖的时候,也不能用量过多,否则会出现不良反应。

5、光合细菌
光合细菌也是我们在养虾的时候,大多数人常采用的一种菌类。而且说实话光合细菌在池塘养殖中是非常有效果的,它能在光照的条件下,生产出各种虾群所需的养分,同时还能通过水体的某些物质进行合成,最终达到净化水质的作用。如果是在缺氧的情况下使用的话,还能起到补充水体氧气的作用。但是光合细菌不能使用金属器皿保存,储存的时间也不长,一般超过半个月就会过期。

其实在养虾的时候,并不是指有着物种菌类是可以用的,像硝化细菌、蛭弧菌、丁酸乳杆菌等着些的效果也是很好的。当然使用什么菌类来养殖,也和地区的气候条件、养殖环境、水体以及个人习惯等各方面有关。此文仅供参考,如果大家还有其他更好的推荐,也可以分享给大家哦。
















